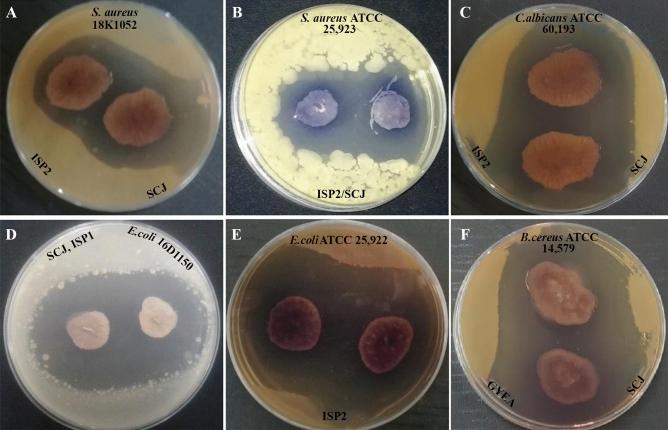
https://cdn.ncbi.nlm.nih.gov/pmc/blobs/b448/10858231/14f8bb35dca3/41598_2024_53801_Fig2_HTML.jpg

从摩洛哥西北部微生物未开发的花园土壤中分离出的蓝色链霉菌 SCJ 的抗菌潜力。
Antimicrobial potential of Streptomyces coeruleofuscus SCJ isolated from microbiologically unexplored garden soil in Northwest Morocco.
机构信息
Laboratory of Agro-Alimentary and Health, Faculty of Sciences and Techniques, Hassan First University of Settat, B.P. 539, 26000, Settat, Morocco.
Laboratory of Biochemistry, Neurosciences, Natural Ressources and Environment, Faculty of Sciences and Techniques, Hassan First University of Settat, B.P. 539, 26000, Settat, Morocco.
出版信息
Sci Rep. 2024 Feb 9;14(1):3359. doi: 10.1038/s41598-024-53801-x.
Research on microorganisms in various biotopes is required to identify new, natural potent molecules. These molecules are essential to control the development of multi-drug resistance (MDR). In the present study, a Streptomyces sp., namely SCJ, was isolated from a soil sample collected from a Moroccan garden. SCJ isolate was identified on the basis of a polyphasic approach, which included cultural, micro-morphological, biochemical, and physiological characteristics. The sequence of the 16S rRNA gene of the SCJ strain showed 99.78% similarity to strains of Streptomyces coeruleofuscus YR- (KY753282.1). The preliminary screening indicated that the SCJ isolate exhibited activity against Candida albicans ATCC 60,193, Escherichia coli ATCC 25,922, Staphylococcus aureus CECT 976, Staphylococcus aureus ATCC 25,923, Bacillus cereus ATCC 14,579, Pseudomonas aeruginosa ATCC 27,853, as well as various other clinical MDR bacteria and five phytopathogenic fungi. The ethyl acetate extract of the isolated strain demonstrated highly significant (p < 0.05) antimicrobial activity against multi-resistant bacteria and phytopathogenic fungi. The absorption spectral analysis of the ethyl acetate extract of the SCJ isolate obtained showed no absorption peaks characteristic of polyene molecules. Moreover, no hemolytic activity against erythrocytes was observed in this extract. GC-MS analysis of the ethyl acetate extract of the SCJ isolate revealed the presence of 9 volatile compounds including 3,5-Dimethylpyrazole, and pyrrolizidine derivatives (Pyrrolo[1,2-a]pyrazine 1,4-dione, hexahydro-3-(2-methylpropyl)), which could potentially explain the antimicrobial activity demonstrated in this study.
需要对各种生境中的微生物进行研究,以鉴定新的天然有效分子。这些分子对于控制多药耐药(MDR)的发展至关重要。在本研究中,从摩洛哥花园采集的土壤样本中分离出一株链霉菌,命名为 SCJ。SCJ 分离株是基于多相方法鉴定的,包括文化、微观形态、生化和生理特征。SCJ 菌株的 16S rRNA 基因序列与蓝色链霉菌 YR-(KY753282.1)菌株的相似度为 99.78%。初步筛选表明,SCJ 分离株对白色念珠菌 ATCC 60,193、大肠杆菌 ATCC 25,922、金黄色葡萄球菌 CECT 976、金黄色葡萄球菌 ATCC 25,923、蜡状芽孢杆菌 ATCC 14,579、铜绿假单胞菌 ATCC 27,853 以及其他各种临床多药耐药细菌和五种植物病原菌真菌具有活性。分离株的乙酸乙酯提取物对多耐药细菌和植物病原菌真菌表现出高度显著的(p<0.05)抗菌活性。SCJ 分离株乙酸乙酯提取物的吸收光谱分析显示,没有特征性的多烯分子吸收峰。此外,该提取物对红细胞没有溶血活性。SCJ 分离株乙酸乙酯提取物的 GC-MS 分析表明,存在 9 种挥发性化合物,包括 3,5-二甲基吡唑和吡咯里嗪衍生物(吡咯并[1,2-a]吡嗪 1,4-二酮、六氢-3-(2-甲基丙基)),这可能解释了本研究中表现出的抗菌活性。